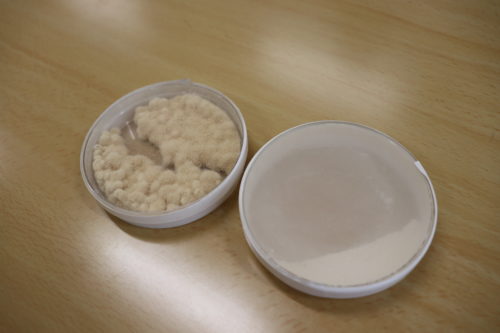

【あたが夢ば叶えてやろたい】ポン酢が好きでたまらない熊本の小学生男子のためにホシサン醤油が動いてくれた
公開日: 2020.01.20
ライター:ムトー- キーワード:
- ホシサン、火の国ポン酢、子供の夢を叶える
老若男女問わず、「叶えたいこと」ってありますよね。
1人の力で頑張って叶えるのも素敵なことなんですが、たまには肥後ジャーナルも世のため人のためになりたい。役に立ちたい。
そう思っていた時に一通のお便りが届きました。
うちの子がホシサンのポン酢が好きで好きでたまりません。もはや中毒レベルと言っても過言ではないのです。
少し目を離すと、ポン酢を飲んでしまいます。
どうにかできませんか?
…どうにかしましょう!!!!
目次
てことでホシサン株式会社へ早速相談してみた

早速やってきました。熊本の醤油味噌といえば、ホシサン株式会社。

今回ご対応頂いたのは、企画部 福島さん

御社のポン酢が好きで好きでたまらなく、飲むほど好きで仕方がないという小学生がおりまして。

ブフォっ!!!(本当に吹き出しました)え?本当ですか?小学生が?

はい。お母さまによりますと、朝から「ごはんにポン酢をかけてくれ」とねだってくるそうです。そして、ないと分かるとそっと涙を流すそうです。

ありがたいお話です。

そこで

そこで?

ホシサンのポン酢がそんなに好きなら夢を叶えてあげたい、なおかつお母さまのご意向「ポン酢飲んでいいのか問題」これを解消したいなと。

夢

大好きなポン酢を普段よりも多く見ることができる夢の空間。
つまり
ポン酢工場見学です。
そしてポン酢飲んでいいのか問題を解消する勉強も。

あ…ポン酢の工場は震災後、見学OKしてないんですよ…。しかも醤油や味噌と違って毎日ラインが稼働しているわけじゃないんで…ただ一度、上席確認させてください。
すぐ決まった

頼んでみたものの無理だろうなと思っていたのですが、お願いをしたその日の夜にまさかのOKをもらいました。めっちゃ迅速ホシサン株式会社。
そしてこの子が今回の主役、熊本市に住むユウキくん(8歳)。
お母さまいわく「ホシサンに行けるんだって」と言われたその夜から興奮が収まらないとの事。


今日はよろしくね!!製造工場見学できるけんね!

うん

なんでそがんポン酢が好きと?

美味しいから
…ガチだ。この子はガチのポン酢好きだ。

社内に案内されるや否や

まずはポン酢撮影

ホシサン株式会社の古荘社長と福島取締役が「ポン酢好きでいてくれてありがとう!!」と感謝の意を伝えていても、視線はポン酢にロックオンのまま。
生粋のポン酢好き。
醤油マスターにまずは醤油について教わった

まずはポン酢の原料の1つである醤油について、正しい知識を学ぶことに。この方は日本に600人程度しか資格を持っていない醤油マスターこと「久吉貴博さん」。
全国各地で醤油について講習をされる、とってもえらい人なんです。

ユウキ君のためにマンツーマンでお勉強をしてくれます。


さてユウキくん、まずはお醤油のクイズです。
お醤油の材料ってなんでしょう?

考えたことがありません…


正解は大豆と小麦そしてお塩です!

それだけ?


そう。基本はそれだけ。でもそれを混ぜるだけでは、いつまでたってもお醤油にはなりません。ちなみにこのペットボトルの中のやつ、いれて3年経つけどそのまんまでしょ。


じゃどうしたらここからお醤油になるんですか?

それはね、麹菌を入れることでお醤油になるんですよ。

これが麹菌。
麹菌、あとは醤油麹やもろみを入れて発酵させることで、初めてお醤油になるんだよ。


色も変わってくるでしょ?右側の一番濃い色のお醤油が「生揚げ(きあげ)醤油」。まだ味の調整とかしてないやつね。
嗅いで見てごらん

スン

クウゥゥゥ…..っ!!!!

相当つらかったようでポン酢に救いを求めてました。

ここから味を調整して
うす口やこい口などを味の種類によってお塩の配合とか変えたりして、食卓に並ぶお醤油になっていくんだよ。
ところでポン酢飲んでいいのか問題


お母さまからのご相談なのですが、ポン酢って飲んでもいいのでしょうか

推奨はできません(笑)
飲むお酢とは違って、そもそも飲料用には使っていないので濃さがやっぱりね…

飲んだらダメてばい。
…めっちゃ泣くの我慢しとるやん!!!

「もう飲みません」と誓ってくれたユウキくん。でも調味料としては使っていいからね!!
お待たせしました!夢の工場見学タイム
お勉強が終わればいよいよ念願の工場見学。
通常、ホシサンの工場見学は味噌だけなのですが、今回特別にポン酢の生産ラインにお邪魔しました!

髪の毛やほこりが入らないよう入念にチェックしたあと、いよいよ中へ!

「すごい…」と小声で感動するユウキくん。分かるよ。本当に感動したときってあまり声に出せないもんね。

できたてのポン酢を触らせてもらえることに

まるでCMのように商品名をカメラに向けてくれました。ありがとう。

作業中にも関わらず製造スタッフの方からも「こっちの方が見えやすかよ!!」など優しいお声がけも。
まとめ

突然の申し出にも関わらず、社長をはじめまさに社員総出で1人の子の夢を叶えてくれたホシサン株式会社。
県内に住む本当に普通の小学生男子の夢を実現させてくれました!
今回、工場を見せていただいた火の国ポン酢は希少なデコポンを惜しみなく使ったポン酢なので、マイルドな口当たり。またその他キッズ用のお醤油なども展開されていましたよ。
ちなみに火の国ポン酢について詳しく知りたい!!という方は以下のリンクボタンからでも検索可能です。
今後も肥後ジャーナルでは、県内在住の方の夢を叶えていきます!自薦他薦問わず募集しておりますので、ご希望の方はぜひ肥後ジャーナルまでご一報ださいませ。
ホシサン株式会社
| 住所 | 熊本県熊本市北区龍田弓削 1-28-8 |
|---|---|
| 電話番号 | 096-338-1100 |
| ホームページ | http://www.hoshisan.co.jp/ |
| 電話番号 | 096-338-1100 |
ライター紹介
ムトー
肥後ジャーナル編集長。 「人はなんで痩せなきゃいけないのかな」という思考にまで達したのでもうきっと痩せません。 気にしません。
ヒゴナルマッチングとは、肥後ジャーナルの媒体を活かして、熊本で自分に合う仕事を探している求職者と求人活動をしている企業の情報をそれぞれ集め、お互いに明確なメリットがあるお仕事探しができる人材情報サービスです。



記事シェア